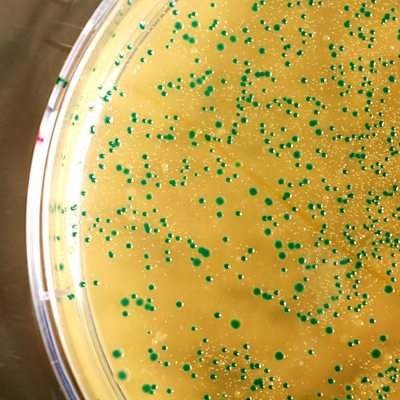

Episode details
Radio 4,17 Aug 2011,30 mins
The Path of Least Resistance
Available for over a year
Last year the Director General of the World Health Organisation forecast that 'the world is heading for a post-antibiotic era'. In July this year a strain of gonorrhea completely resistant to antibiotics was identified in Japan, with the warning that the infection could now become a global threat to public health. Dr Stuart Flanagan works in a sexual health clinic and regularly treats patients with gonorrhea. So far the resistant strain hasn't arrived in the UK but, with international travel and the established pattern of migration shown by other resistant bacteria, it won't be long. It's inevitable that bacteria will evolve and the ones able to resist the antibiotics aimed to kill them - the fittest - will survive. But over-prescription, failure to complete courses, and factors such as poor hygiene have all contrived to help bacteria become resistant. For immuno-suppressed patients, like those with HIV or undergoing chemotherapy, resistant bacteria can prove fatal. Over 80% of antibiotics in the UK are prescribed by GPs; Stuart Flanagan hears from Professor Chris Butler, Head of Primary Care and Public Health at Cardiff University about the STAR study, aimed at reducing antibiotic prescribing, and from Dr Jennifer Byrne of Queens Medical Centre, Nottingham, about treating immuno-suppressed patients. Dr David Livermore of the Health Protection Agency explains how we've helped resistance to grow. Especially in the developing world, where poverty and fake medicines exacerbate the situation. Newly affluent India and China, show resistance levels as high as 60%. And Otto Cars of ReAct - an independent global network tackling antibiotic resistance - considers the global options. The Chief Medical Officer, Dame Sally Davies, reflects on the UK's role.
Programme Website